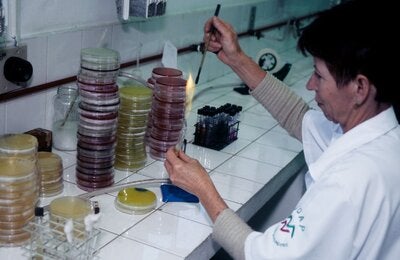
© PAHO/WHO

The negative effects of zoonoses are far reaching. High incidence rates continue to cause significant morbidity and mortality in both humans and animals. Their economic impact is seen in lost labor productivity due to illness; reduced travel and tourism to affected areas; reduced livestock and food production; death and destruction of affected animals; and restrictions on and reductions in international trade. Zoonoses can be a serious drain on a country’s economy, which in turn can have wide repercussions for a society’s health.
In the vast majority of cases, animal source intervention or control could prevent subsequent public health problems, therefore, integrated interventions should be implemented to address the underlying factors responsible for intersectoral health problems. Consequently, seeking solutions to these challenges, in view of their intricacy, involves an approach through cooperation at the intersectoral level within the framework of “One Health”, calling for input, participation and collaboration of professional teams across human, animal and environmental health sectors.
Photo Exhibit Homepage